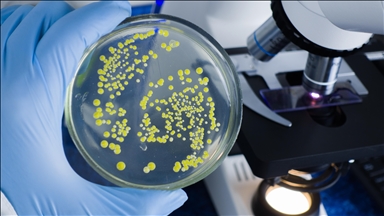
U ledenoj pećini u Rumuniji pronađena 5.000 godina stara bakterija otporna na antibiotike

Rumunija uvodi nova ograničenja putovanja zbog varijante koronavirusa omikron
Svi putnici koji dolaze izvan EU-a moraju imati negativan PCR test prije ulaska u zemlju
 Foto: Arhiv AA
Foto: Arhiv AA
Bukurešt
Rumunija uvodi nova ograničenja putovanja u cilju sprečavanja širenja COVID-19 nakon što je u ovoj zemlji otkrivena varijanta koronavirusa omikron, javlja Anadolu Agency (AA).
Nacionalni komitet za vanredne situacije (CNSU) u ponedjeljak naveče odobrio je nova pravila za putnike koji dolaze u zemlju, koja će biti na snazi od 10. decembra do 8. januara.
Svi putnici koji dolaze izvan Evropske unije (EU) moraće imati negativan PCR test uzet 48 sati prije ulaska u zemlju, čak i ako su u potpunosti vakcinisani.
Putnici iz zemalja EU-a moraju imati potvrde da su potpuno vakcinisani.
U Rumuniji, koja ima oko 20 miliona stanovnika, do sada je registrovano više od 1,7 miliona slučajeva zaraze koronavirusom, a 57.260 osoba je preminulo. Potpuno vakcinisano je oko 39 posto stanovništva.
Na internet stranici Anadolu Agency (AA) objavljen je samo dio sadržaja vijesti koje su putem našeg Sistema protoka vijesti (HAS) dostupne korisnicima. Molimo da nas kontaktirate za pretplatu.